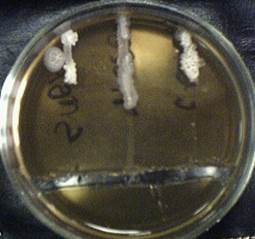

Влияние антибиотиков на развитие микроорганизмов
Рисунок 1. Чувствительность микроорганизмов (Bacillus subtilis, Bacillus mesentericus, Bacillus cereus – на рисунке слева направо) к бензилпенициллину.

Приложение 2
Рисунок 2. Чувствительность микроорганизмов (Bacillus subtilis, Bacillus mesentericus, Bacillus cereus – на рисунке слева направо) к ампициллину.